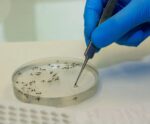
Saúde alerta para disseminação da febre Oropouche no país

Fátima Bernardes revela que doença motivou saída do 'Encontro'
Fátima contou que não precisou fazer tratamentos mais agressivos como rádio ou quimioterapia, pois o câncer foi detectado no início

Fátima contou que não precisou fazer tratamentos mais agressivos como rádio ou quimioterapia, pois o câncer foi detectado no início

A Campanha Nacional de Vacinação contra a Poliomielite vai até 14 de junho. A expectativa é reduzir o número de crianças não imunizadas e o risco de reintrodução do poliovírus no Brasil

A descoberta sobre a circulação entre pessoas, inclusive na zona urbana de Roraima, acende um alerta para a possibilidade de disseminação pelo país

Um hematoma subdural ocorre quando sangue se acumula entre o crânio - mais especificamente dura-máter que é uma membrana que envolve todo o cérebro

Para 2024, projeções do Ministério da Saúde, por meio do Instituto Nacional do Câncer (Inca), apontam 14 mil casos novos em mulheres e 18 mil em homens

De acordo com o médico, é fundamental buscar auxílio profissional para tratar as dores
Os demais casos foram registrados ou estão em investigação na Bahia, Acre, Espírito Santo, Pará, Rio de Janeiro, Piauí, Roraima, Santa Catarina, Amapá, Maranhão e Paraná

Para conseguir arrecadar a quantia, familiares e amigos vão promover uma feijoada solidária no dia 16 de junho

No período de 23 de abril até esta sexta-feira (10), foram registrados 56 casos da doença. Nenhum óbito foi registrado no Espírito Santo

Além da infecção na córnea outros problemas oculares podem ser evitados com a higienização correta das mãos

A Febre do Oropouche é uma doença causada por um arbovírus (vírus transmitido por artrópodes) do gênero Orthobunyavirus, da família Peribunyaviridae

De acordo com o boletim, no período de 23 de abril até esta quinta-feira (2), não foi registrado nenhum óbito pela doença